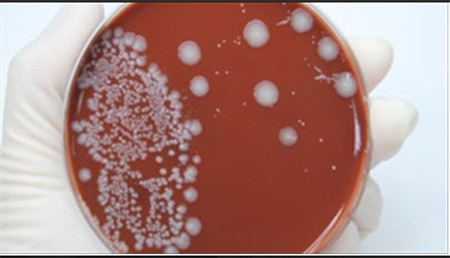
{keywords}

Không chỉ có khả năng nhiễm bệnh đến 80% sau 1 lần quan hệ tình dục không an toàn mà bệnh lậu còn gây hệ lụy nghiêm trọng là nguy cơ vô sinh, thậm chí tử vong nếu như không phát hiện và điều trị kịp thời.
20- 80% người nhiễm bệnh sau 1 lần “không an toàn”
N.T.T (25 tuổi, ngụ tại Quận 10) đến Đa khoa Quốc tế (221, Nguyễn Thị Minh Khai, Quận 1) đăng ký khám phụ khoa vì dạo này bản thân cô thấy “vùng kín” có nhiều biểu hiện rất lạ. Một số biểu hiện đó có thể kể đến như: khí hư ra rất nhiều, màu vàng, mùi hôi. Bên cạnh đó, mỗi khi đi tiểu cô có cảm giác buốt, rát, vùng bụng dưới liên tục bị đau.
Sau khi nghe chia sẻ của bệnh nhân kết hợp với thăm khám lâm sàng, bác sĩ Huỳnh Mai chỉ định cho cô làm thêm một số xét nghiệm khác. Kết quả cuối cùng cho thấy, cô dương tính với vi khuẩn Neisseria gonorrhoeae (vi khuẩn gây bệnh lậu) và căn nguyên là do trong một lần say xỉn không làm chủ được mình cô đã để xảy ra quan hệ tình dục với một người bạn trai trong nhóm (người này trước đó cũng bị nhiễm lậu).
![]() |
| Vi khuẩn lậu cầu dưới kính hiển vi |
Tương tự như trường hợp của bệnh nhân T, một bệnh nhân nam ngụ tại Bình Phước cũng vô tình nhiễm lậu bởi tình huống trớ trêu như vậy. Khi đến khám tại Đa khoa Quốc tế, bệnh nhân này cho biết: “Sau khi quan hệ tình dục với gái mát-xa được 10 ngày thì tôi bắt đầu thấy cơ thể có nhiều dấu hiệu vô cùng khó chịu. Ví dụ như: đầu dương vật ngứa, các mép ở đầu dương vật bị tấy đỏ. Mỗi khi đi tiểu có cảm giác nóng, buốt, tiếp đó là thấy mủ chảy ra ở đầu dương vật có màu trắng đục”.
Nhiều biến chứng khó lường
Các bác sĩ Đa khoa Quốc tế cho biết, bệnh lậu là một trong những bệnh nhiễm khuẩn lây truyền qua đường tình dục tương đối phổ biến, chiếm 3 - 15% trong tổng số các bệnh lây truyền qua đường tình dục. Tác nhân gây bệnh là vi khuẩn Neisseria gonorrhoeae, thời gian ủ bệnh từ 3 - 5 ngày. Căn bệnh này gặp ở mọi lứa tuổi từ sơ sinh đến người cao tuổi. Tuy nhiên, lứa tuổi trẻ hoạt động tình dục mạnh là phổ biến nhất.
Lậu nếu không được phát hiện và điều trị sớm có thể chuyển từ giai đoạn cấp tính sang mãn tính với nhiều biến chứng nguy hiểm. Ở nam giới: lậu có thể gây viêm niệu đạo, viêm các tuyến khu trú cạnh dây hãm ở rãnh quy đầu, viêm các ống và các tuyến khu trú cạnh miệng sáo, viêm tuyến Littre và tuyến Cowper, viêm ống dẫn tinh và mào tinh hoàn, viêm túi tinh và ống phóng tinh,...
![]() |
| BS. Mai cho biết, lậu cầu không chỉ lây lan nhanh mà còn gây ảnh hưởng xấu tới khả năng sinh sản và tính mạng của người bệnh |
Ở nữ giới có thể gây viêm niệu đạo, viêm cổ tử cung có mủ, viêm âm hộ, âm đạo, có khi viêm tuyến Bartholin, viêm tuyến Skène. Các viêm nhiễm này lâu dần sẽ lan lên tử cung, vòi trứng, buồng trứng,...
Các biến chứng toàn thân gặp ở cả nam và nữ bao gồm: viêm hậu môn - trực tràng, viêm đau họng, viêm khớp, viêm nội tâm mạc và viêm kết mạc dẫn đến loét giác mạc, thủng giác mạc (gặp ở trẻ sơ sinh)...
BS. Huỳnh Mai chuyên khoa phụ sản, phòng khám Đa khoa Quốc tế cho biết, với các biến chứng trên người bệnh không chỉ phải đối mặt với tình trạng vô sinh mà nguy hiểm hơn khi viêm nhiễm lan rộng đến ổ bụng, gây tắc ruột hoặc nhiễm khuẩn huyết có thể dẫn đến tử vong. Mặc dù tỷ lệ gây tử vong rất thấp nhưng không có nghĩa là không xảy ra. Vì vậy, khi có dấu hiệu của bệnh nên đi khám và điều trị càng sớm càng tốt.
| Với thế mạnh trong khám và điều trị các bệnh lý nam khoa, phụ khoa, bệnh lây truyền qua đường tình dục, Đa khoa Quốc tế (221, Nguyễn Thị Minh Khai) đã đạt được nhiều thành tựu nổi bật, trở thành điểm đến đáng tin cậy của hàng nghìn bệnh nhân khu vực TP.HCM và một số tỉnh lân cận.
Ngoài ra, với môi trường y tế đạt chuẩn sẽ tạo cho người bệnh cảm giác thoải mái, an toàn, hồ sơ bệnh án được bảo mật tuyệt đối. Đặc biệt để được hỗ trợ tư vấn sức khỏe sinh sản miễn phí, bạn có thể gọi đến: (08)39 257 111 hoặc 08 3925 7222. Website: http://dakhoaquocte.vn Email: phongkhamdakhoaquocte@gmail.com |
Phương Dung